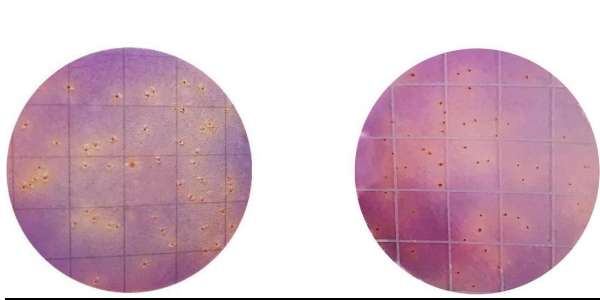
MicroFast Enterobacteriaceae Count Plate

Описание
Подложка MicroFast Enterobacteriaceae Count Plate (EB) представляет собой простую и готовую систему с питательной средой, в которой используются инновационные технологии, такие как системы быстрой диффузии и микробное окрашивание нового поколения, для достижения быстрого распределения образца и интерпретации колоний, что значительно повышает эффективность анализа в лаборатории.
Подложка содержит готовую питательную среду, гель растворимый в холодной воде и индикатор (трифенилтетразолий хлорид). Подложка предназначена для подсчета бактерий сем.Enterobacteriaceae в пищевых продуктах, питьевой воде, сырье и образцах окружающей производственной среды пищевых продуктов.
Особенности применения MicroFast Enterobacteriaceae Count Plate
- Инкубируйте подложку MicroFast в горизонтальном положении пленкой вверх стопками не более 20 штук.
- Инкубация при 35 ± 0.5°C в течение 18 — 24 ч.
- Подсчитывают все красные колонии с жёлтым ореолом с/без пузырьков газа
- Высокие концентрации колоний — вся зона роста обесцвечивается
Преимущества MicroFast Enterobacteriaceae Count Plate
- Быстрый и точный анализ: подложка обеспечивает быстрое определение количества микроорганизмов в образцах.
- Простота использования: процесс проведения анализа не требует специальных навыков и легко осуществим даже для непрофессионалов.
- Надежность результатов: благодаря высокой чувствительности и специфичности подложки можно быть уверенным в достоверности полученных данных.
- Эффективность: подложка позволяет быстро выявить возможные источники загрязнения и принять меры по их устранению.
По сравнению с традиционными чашками Агар-Петри:
- Экономия места: компактная конструкция снижает потребность в хранении.
- Сокращаются лабораторные расходы: не требуется подготовка среды и меньшее количество необходимого оборудования.
- Повышается экономическая эффективность: упрощается рабочий процесс, повышается производительность.
- Сокращается время тестирования: результаты получаются быстрее по сравнению со стандартными чашками с агаром.
В сегодняшних условиях повышенного внимания к безопасности пищевых продуктов и все более строгих требований к качеству лаборатории вынуждены проводить быстрые, надежные и неизменно точные тесты. Пластины MicroFast демонстрируют стабильную производительность, что было отмечено международным валидационным органом АОАС. Тест-пластины MicroFast позволяет стандартизировать и упростили процесс количественного тестирования микроорганизмов, повышая производительность и помогая обеспечить высочайший уровень качества продукции.
Компания Meizheng Bio-Tech Co., Ltd сертифицирована Международной организацией по стандартизации (ISO) 9001 для проектирования и производства.
































